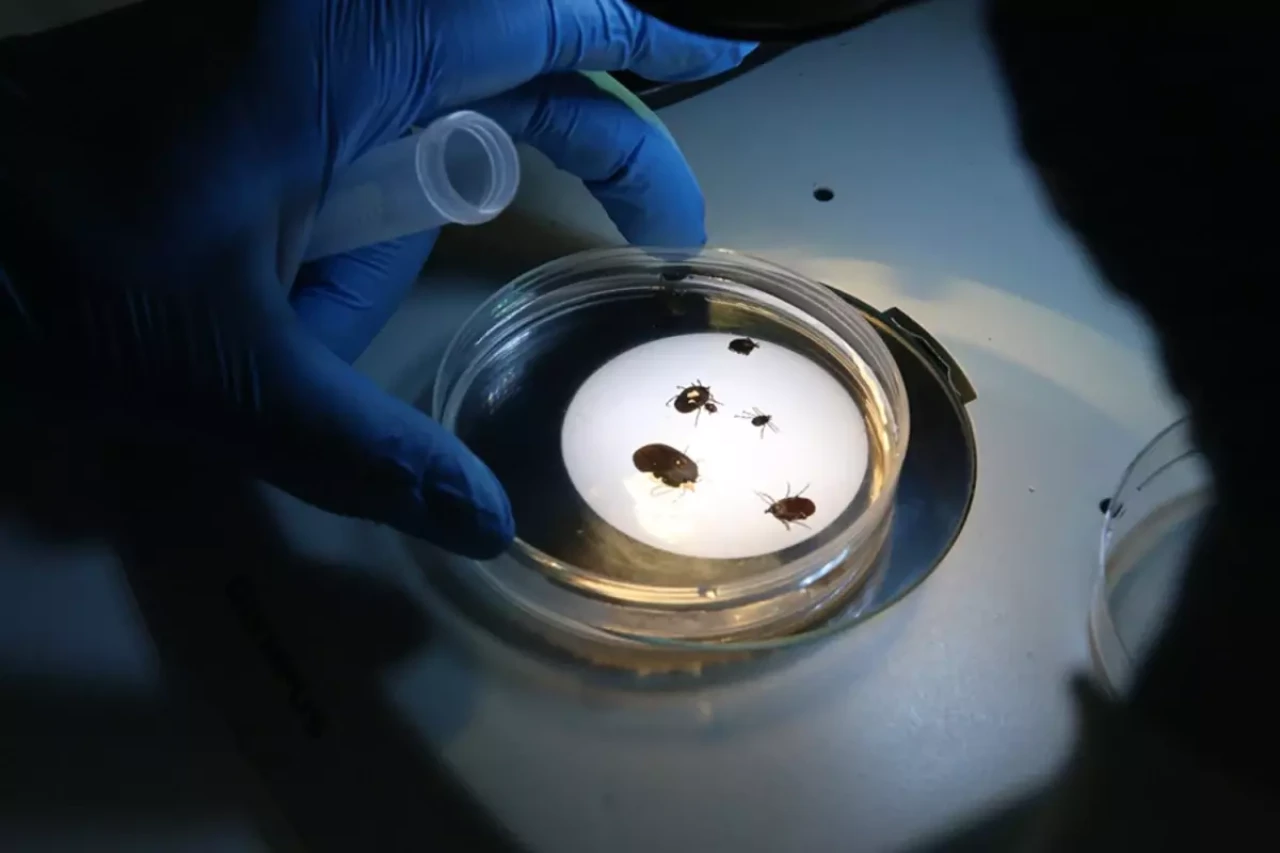

İstanbul’da Bulundu, Çin’den Gelmiş Olabilir
Tokat Gaziosmanpaşa Üniversitesi'nden (TOGÜ) çarpıcı bir açıklama geldi. Fen-Edebiyat Fakültesi Biyoloji Bölüm Başkanı Prof. Dr. Adem Keskin, Türkiye'de ilk kez tespit edilen Haemaphysalis longicornis adlı istilacı bir kene türünün varlığını kamuoyuna duyurdu. Prof. Dr. Keskin’in Japonya’dan bilim insanı Dr. Kandai Doi ile birlikte yürüttüğü çalışmalar sonucu elde edilen bulgular, uluslararası bilim camiasında da yankı uyandırdı.
Geçtiğimiz yıl İstanbul'da bir vatandaşın vücudunda tespit edilen ve laboratuvara ulaştırılan bu kene türü, yapılan detaylı analizler sonucunda Asya kökenli Haemaphysalis longicornis olarak tanımlandı. Prof. Dr. Keskin, kenenin büyük ihtimalle Çin menşeli olduğunu ve artık Türkiye doğasında yerleşik hale geldiğini ifade etti.
Uluslararası Bilimsel Yayında Türkiye'den İlk Kayıt
Bu önemli keşif, alanında saygınlığıyla bilinen “Experimental and Applied Acarology” adlı uluslararası bilimsel dergide yayımlandı. Bu yayın sayesinde hem ülkemizdeki biyolojik çeşitliliğe dair farkındalık arttı hem de kene kaynaklı olası risklere dikkat çekildi. Keskin, konuyla ilgili yaptığı açıklamada, “Bu kene türünü yaklaşık 3-4 yıl önce ülkemize giriş yapmış olarak değerlendiriyoruz. Eylül ayından bu yana sahada düzenli örnekler topluyor, gelişim evrelerini gözlemliyoruz. Larva, nimf ve ergin dişi evrelerini tespit ettik, bu da artık burada ürediklerini ve tutunduklarını gösteriyor,” ifadelerine yer verdi.
56. Kene Türü Oldu, Hastalık Riski Büyük
Haemaphysalis longicornis’in Türkiye'de tanımlanan 56. kene türü olduğunu belirten Prof. Dr. Keskin, bu türün taşıdığı risklerin hafife alınmaması gerektiğini vurguladı. Bilimsel verilere göre, bu kene türü 30'dan fazla hastalık etkenini taşıma potansiyeline sahip. Daha önce Türkiye'de bilinen en tehlikeli kene türlerinden biri olan Hyalomma marginatum gibi, yüksek vektör kapasitesi bulunan bu yeni tür, özellikle insan ve hayvan sağlığı açısından ciddi tehdit oluşturuyor.
Üniversite rektörlüğünün desteklediği proje kapsamında bu türün popülasyon hareketleri, yayılma dinamikleri ve taşıyabileceği potansiyel patojenler detaylı şekilde izleniyor. Çalışmalar sadece akademik düzeyde kalmayıp, halk sağlığı açısından da ciddi stratejilere zemin hazırlayabilecek nitelikte.
Asya’dan Amerika’ya, Şimdi de Türkiye’de
Araştırmanın diğer ayağını yürüten Japon bilim insanı Dr. Kandai Doi, bu kene türünün özellikle Çin ve Avustralya'da yaygın olduğunu ve 2017’den itibaren ABD’ye kadar ulaştığını belirtti. ABD’de hayvan hastalıkları başta olmak üzere, çiftlik ekonomisi ve veterinerlik alanlarında ciddi sağlık sorunlarına yol açtığı kaydedildi. Dr. Doi, Türkiye’de ilk kez bu türün tespit edilmesini kayda geçtiklerini belirterek, “İstilacı bir tür olarak insan sağlığı açısından büyük bir tehdit oluşturuyor. Bu sebeple dikkatli bir şekilde izlenmesi gerekiyor,” dedi.